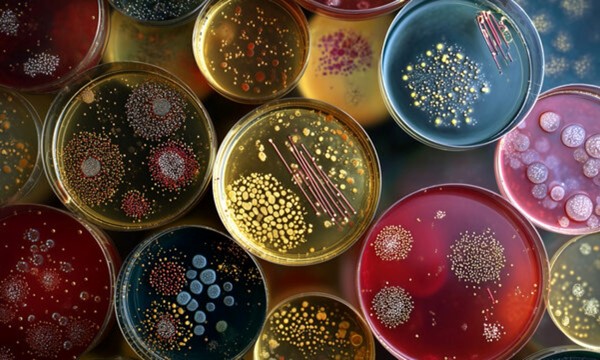

Microbiology Ubiquity Experiment Event
Microbiology Ubiquity Experiment Event Join us for our second AMSA General Body Meeting on the Boca Raton campus! We will be discussing our exciting upcoming events and will also dive into the famous Microbiology Ubiquity experiment. This is a fantastic opportunity to learn a key Microbiology technique and perform a favorite experiment in the lab curriculum! You will also be contributing to our Microbiome Portal project where we will be swabbing bacteria from commonly used surfaces on campus. Don't miss out on this hands-on experience and chance to connect with fellow AMSA members. See you there! From
to
at CA107.
Latest PBSC Engage!
- Essentials of Celestial MechanicsEssentials of Celestial Mechanics From to at Room CRA 203.
- The Financial Statement Blueprint: Decoding Your Next InvestmentThe Financial Statement Blueprint: Decoding Your Next Investment Join the Accounting & Finance Investing Club (AFIC) as we break down how to do your own financial analysis to determine if a company is a 'loser' or a 'winner.' We'll be joined by guest speaker Ahmad Joarder (AJ the CPA), a former Deloitte auditor who will add his professional insights to our discussion. Don't miss this chance to learn from a seasoned professional! AJ the CPA From to at CBP203 Lake Worth Campus.
- The Creation of the World and Other BusinessThe Creation of the World and Other Business Description The Creation of the World and Other Business by Arthur Miller presented by Palm Beach State College Theatre Department Ticket Information Thursday - 10/23 - Saturday 10/25 @ 7:30pm & Thursday - 10/30 - Saturday 11/01 @ 7:30pm All Seats $12 General Admission | Buy Tickets | Box Office: 561-868-3309 About the Performance Breathing new life into timeless biblical tales, Arthur Miller charmingly reimagines the Book of Genesis from the temptation of Adam and Eve to the fraternal tragedy of Cain and Abel. In the beginning, God, generally satisfied with his creation, is nonetheless perplexed by Adam and Eve—why won’t they multiply? It takes wily Lucifer to interest them in anything more than playing handball in the Garden of Eden, but their new knowledge comes at a price. The first family is exiled from paradise—just as Lucifer is banned from heaven—and a fallen, morally ambiguous state becomes the destiny of humankind. Though The Creation of the World and Other Business was Arthur Miller’s first Broadway comedy, it is full of the searching insight and sparkling dialogue that distinguish his best dramas. *All programs, artists, dates, prices, and times are subject to change. Seating is subject to availability. Additional charges will apply to all phone, mail, fax & online ticket orders. * From to at Duncan Theatre.
- Bookstore Financial Aid DeadlineBookstore Financial Aid Deadline Fall 2025 | Express B Last day to use financial aid at campus bookstores Friday, Oct. 24, 2025 Learn more at Using Financial Aid | Bookstore From to at Palm Beach State College.
- Community Earth Club Meeting - Pumpkin Carving - RSVP by 10/21!Community Earth Club Meeting - Pumpkin Carving - RSVP by 10/21! Join the Community Earth Club for our Pumpkin Carving Event (Saturday, Oct 25th | 10 AM – 12 PM)! Note: Students MUST RSVP by Tuesday, October 21st! From 10 am to 12 pm, we will be pumpkin carving on campus! Then, members can leave their pumpkins with our club advisor to bring to MacArthur Beach State Park. From 6 to 9 pm, members can head over to MacArthur Beach State Park to stroll along the boardwalk, lit up with all of our Jack-o-lanterns! *Pumpkins, carving tools, templates, and snacks will all be provided* Students are welcome to bring their own designs to carve as well! We'd love to see you there! #CommunityEarthClub #PBSC #Sustainability #GetInvolved #EcoWarriors From to at Amphitheatre.
- Making Strides Against Breast CancerMaking Strides Against Breast Cancer Breast cancer has affected too many people I love, my grandmother and friends. That's why I've joined Making Strides Against Breast Cancer to honor survivors and thrivers, remember those we've lost, and offer up support to anyone in our community who's been affected by it. Join Making Strides HESO Team by walking or volunteering in this valuable event. Funds raised will sustain critical research and provide services for people trying to cope with their breast cancer experience. Please email me, Priscilla, President of HESO at sandovalpa1@my.pbsc.edu when you join our team whether you are walking or volunteering so we can participate as a team to show Panter Pride. Click the link below to join HESO'S Team "Making Strides Against Breast Cancer." http://main.acsevents.org/goto/HESOPBSCFIU From to at SUNSET COVE AMPHITHEATER .